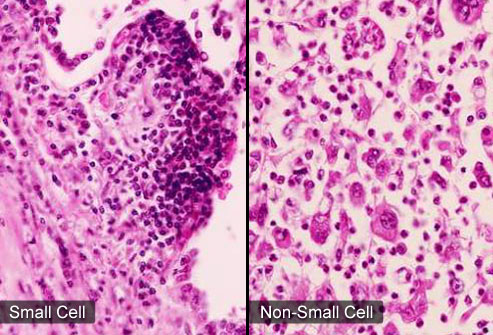
Small-cell Carcinoma - Hình ảnh minh họa

Triệu chứng
Triệu chứng Small-cell Carcinoma, SCC hay Ung thư phổi tế bào nhỏ là Ho, đau ngực, đờm có máu, giảm cân không chủ ý, khó thở và suy nhược.
Chẩn đoán
Hỏi bệnh sử và khám thực thể.
Các xét nghiệm được thực hiện để xác định mức độ của bệnh.
Sinh thiết phế quản hay mô phổi thường được thực hiện để xác định loại ung thư.
Đôi khi loại tế bào ung thư có thể được xác định bằng cách phân tích mẫu đờm.
Chụp cắt lớp vi tính (CT Scan), chụp cộng hưởng từ (MRI), chụp cắt lớp phát xạ Positron (PET) và quét X-quang.
Xét nghiệm công thức máu toàn bộ (CBC).
Điều trị
1/4
Click vào ảnh để xem 4 hình ảnh minh họa
Điều trị Small-cell Carcinoma, SCC hay Ung thư phổi tế bào nhỏ tùy thuộc vào mức độ của bệnh, có thể bao gồm phẫu thuật, hóa trị và xạ trị.